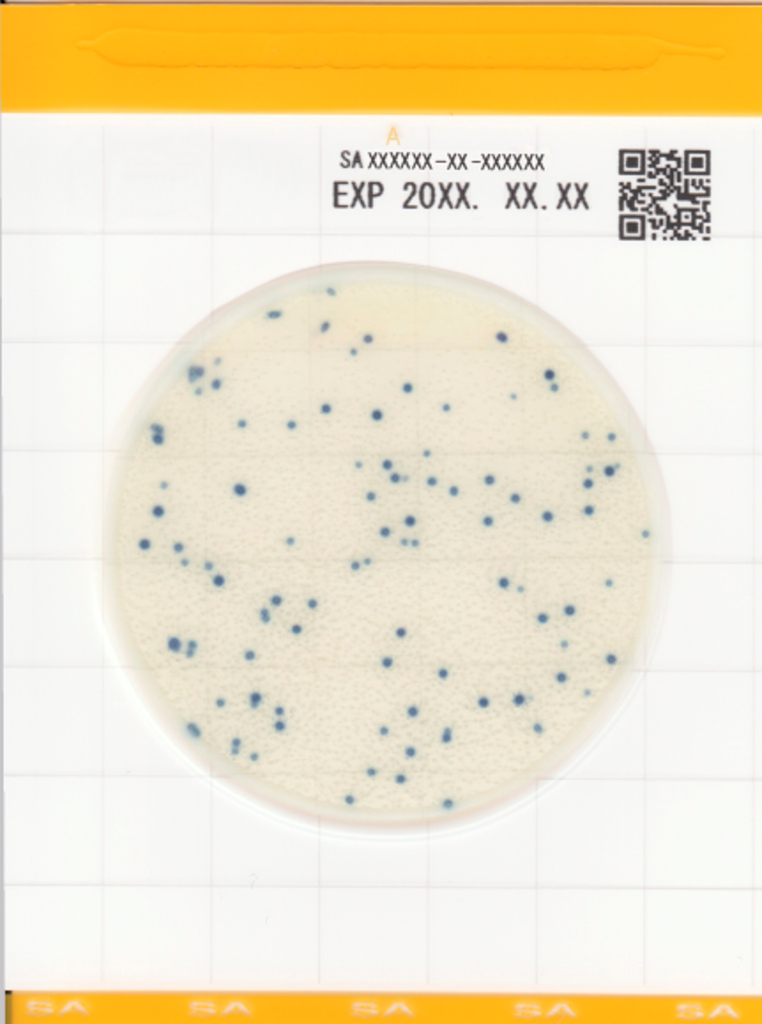

Easy Plate SA
- Einfache Handhabung, zuverlässige Ergebnisse
- AOAC PTM-zertifiziert
- Hohe Spezifität
- Sofort einsatzbereit, Probensuspension auf die Platte geben und inkubieren
- Sehr geringer Platzbedarf beim Inkubieren und wenig Abfall
Selbstdiffundierend, präzise, zertifiziert (AOAC-PTM, MicroVal), REDUZIERT Platz, Zeit und Abfall. Für Staphylococcus aureus
Easy Plate SA ist eine mikrobiologische Plattenmethode, die aus einem wasserdichten Papier mit einem vorgefertigten Trockenmedium und einer transparenten Abdeckung über dem Medium besteht. Die Easy Plate SA-Methode dient zur Bestimmung des Gehalts an Staphylococcus aureus in Lebensmitteln.
Die Platten sind kompakt, einfach in der Anwendung und reduzieren die Gesamtabfallmenge, die bei der Verwendung des Tests entsteht. Die Easy-Plate-SA-Methode wurde vom AOAC Research Institute als 'Performance Tested MethodsSM (111703)' für elf Lebensmittelmatrices zugelassen: rohes Hackfleisch, rohes Lammfleisch, gekochter Schinken, roher Lachs, gefrorene Garnelen, frische gekühlte Nudeln, pasteurisierte Milch, Naturkäse, Windbeutel und Kartoffelsalat.
Für die Vorbereitung der Platten zum Inkubieren sind keine zusätzlichen Hilfsmittel erforderlich. Dies ist dem hydrophoben Ring, um die Kulturfläche zu verdanken, der beim automatischen Verteilen der Probe auf der Kulturfläche hilft.
1x 100 Platten/Packung
Target microorganisms: Staphylococcus aureus
Article Number: 61983
Incubation time: 24 hrs +/- 1hrs
Incubation temperature: 35°C +/- 1°C, 37°C +/- 1°C
Shelf life: 18 months after manufacturing
Storage: 2-8°C
Bereiten Sie die Probe gemäß der Anleitung vor.
Nehmen Sie 1 ml der Probenlösung mit einer Pipette auf und klappen Sie den Deckel der Platte auf. Pipettieren Sie die Probenlösung auf die Platte und schließen Sie den Deckel.
Entsprechend der Anleitung inkubieren.
- Easy Plate SA SA20260312A exp 11.03.2027.pdf
- Easy Plate SA SA20260217A exp 16.02.2027.pdf
- Easy Plate SA SA20260129B exp 28.01.2027.pdf
- Easy Plate SA SA20260128A exp 27.01.2027.pdf
- Easy Plate SA SA20260127A exp 26.01.2027.pdf
- Easy Plate AC20251125A exp 24.05.2027.pdf
- Easy Plate SA SA20251224B exp 23.12.2026.pdf
- Easy Plate SA20251212B exp 11.12.2026.pdf
- Easy Plate SA SA20251128B exp 27.11.2026.pdf
- Easy Plate SA SA20251128A exp 27.11.2026.pdf
- Easy Plate SA SA20251015A exp 14.10.2026.pdf
- Easy Plate SA SA20251016A exp 15.10.2026.pdf
- Easy Plate SA20250613A exp 12.06.2026.pdf
- Easy Plate SA20250616A exp 15.06.2026.pdf
- Easy Plate SA SA20250324B exp 23.03.2026.pdf
- Easy Plate SA SA20250320A exp 19.03.2026.pdf
- Easy Plate SA SA20250219A exp 16.02.2026.pdf
- Easy Plate SA SA20250127A exp 26.01.2026 .pdf
- 61976_SA20250123B.pdf
- 61976_SA20250123A .pdf
- 61976_SA20241106A .pdf
- 61976_SA20241021A.pdf
- 61976_SA20241107A .pdf
- Easy Plate SA SA20241021A exp 20.10.2025.pdf
- Easy Plate SA SA20240917A exp 16.09.2025 .pdf
- Easy Plate SA SA20240902B exp 01.09.2025.pdf
- Easy Plate SA SA20240902A exp 01.09.2025 .pdf
- Easy Plate SA SA20240801A exp 31.07.2025.pdf
- Easy Plate SA SA20240716A exp 15.07.2025.pdf
- Easy Plate SA SA20240625B exp 24.07.2025 .pdf
- Easy Plate SA - SA20240202A - exp 01.02.2025.pdf
- Easy Plate SA - SA20231219A - exp 18.12.2024.pdf
- Easy Plate Sa - SA20240321A - exp 20.03.2025.pdf
- Easy Plate SA - SA20240222B - exp 21.02.2025.pdf